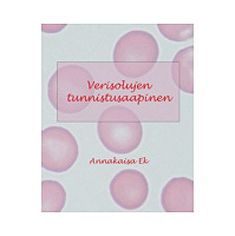
main product photo

Annakaisa Ek : Verisolujen tunnistusaapinen
€44.70
In stock
Only %1 left
SKU
P-VERI-A05247

Verisolujen tunnistusaapinen offers an in-depth overview of the microscopic identification of MGG-stained blood cells, essential for early-career hematology professionals. The book guides the reader from recognizing normal cells to identifying pathological changes in blood cell development.
Click to see Finnish description
| Categories | |
|---|---|
| Author | Annakaisa Ek |
| Title | Verisolujen tunnistusaapinen |
| SKU | P-VERI-A05247 |